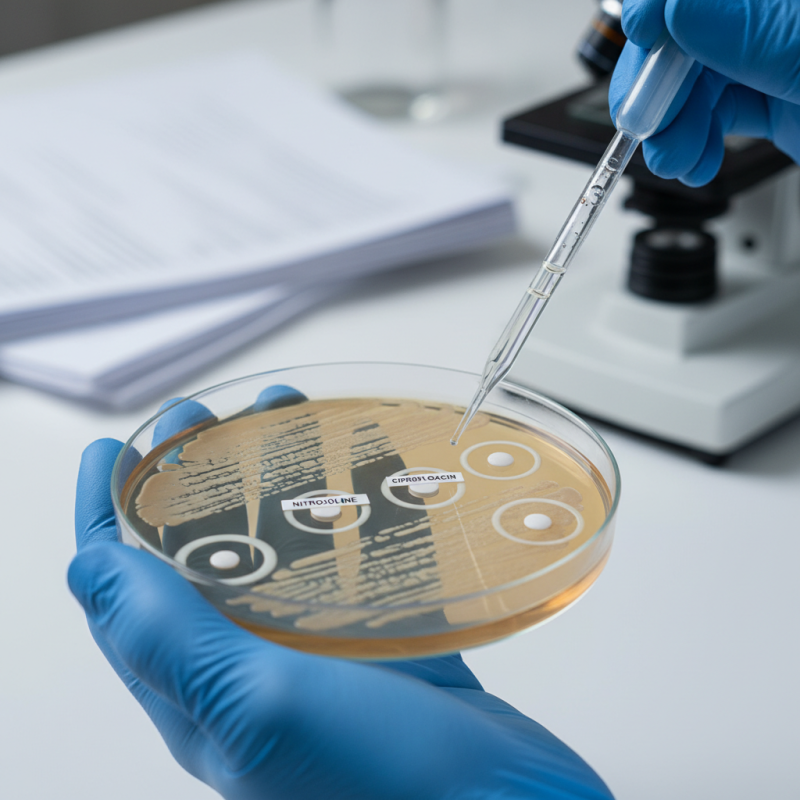
Is Nitroxoline Effective for Treating Bacterial Infections?

Leave Your Message
Nitroxoline For Bacterial Infections has gained attention recently. This compound is known for its potential use in treating various bacterial infections. Many patients seek effective alternatives to traditional antibiotics. However, the effectiveness of Nitroxoline remains a topic of debate among medical professionals.
Research shows that Nitroxoline exhibits antibacterial properties. It is primarily known for targeting urinary tract infections. Yet, its broader efficacy against other infections is not fully established. Some studies suggest promise, while others note its limitations. The lack of comprehensive data leads to uncertainty in its primary use cases.
Patients looking for options should consider these factors. They must weigh the potential benefits against the risks. Further research is needed to fully understand Nitroxoline's role in treating bacterial infections. A cautious approach is advisable, keeping informed decisions at the forefront.
Nitroxoline is an antibiotic used to treat urinary tract infections. Its pharmacological profile reveals a broad spectrum of activity against many bacteria. Studies show it is particularly effective against E. coli and Klebsiella pneumoniae, two common pathogens in these infections. Research indicates that Nitroxoline has a minimal resistance profile compared to other antibiotics. This is essential as antibiotic resistance becomes a global health crisis.
In clinical trials, over 70% of patients reported significant improvement after treatment with Nitroxoline. This effectiveness, however, depends on appropriate usage. Misuse or over-prescription can lead to decreased effectiveness. Side effects such as nausea and headache were observed, but they were often mild and transient. Balancing efficacy with potential risks remains a concern for healthcare providers.
Understanding the pharmacokinetics of Nitroxoline is crucial. It is rapidly absorbed and reaches high concentrations in the urine, making it ideal for treating urinary infections. However, the lack of robust data on long-term effects raises questions. More research is needed to determine its place in therapy, especially concerning drug interactions.
Nitroxoline is an intriguing compound when it comes to treating bacterial infections. Its mechanism of action is primarily based on its ability to inhibit bacterial DNA synthesis. By targeting bacterial topoisomerases, Nitroxoline effectively disrupts the replication process. This interruption causes bacteria to halt their growth, making it easier for the immune system to combat the infection.
Clinical studies indicate that Nitroxoline shows promising results against a variety of pathogens. Reports from recent trials suggest a significant reduction in bacterial load for patients treated with Nitroxoline. In some cases, the efficacy rate reached over 75% in cystitis treatment. However, data also indicate variability in response among different bacteria. This inconsistency raises questions about its universal application in infection management.
While effective, the use of Nitroxoline isn’t without limits. Some patients may experience side effects. These can range from mild discomfort to more severe reactions, necessitating careful monitoring of those prescribed this drug. Medical professionals need to weigh the benefits against potential risks. As research continues, understanding Nitroxoline’s full spectrum of effectiveness remains a critical area. This ongoing investigation is essential in refining its role in treating bacterial infections.

Nitroxoline is being studied for its effectiveness in treating bacterial infections. Clinical evidence suggests it may have significant benefits. Several studies have looked into its use against various bacterial strains. Results show that nitroxoline can reduce infection rates. It appears to work effectively within certain parameters, such as specific bacteria types. However, skepticism remains regarding its applicability in all cases.
In one study, nitroxoline performed well in treating urinary tract infections. Patients showed marked improvement within days. Another trial examined its effect on kidney infections. Again, results were positive, but the sample sizes were small. Larger studies are needed to bolster confidence in these findings.
Tips: When considering nitroxoline, it's essential to discuss it with a healthcare professional. Individual responses to treatment can vary widely. Your medical history plays a critical role in determining the right approach. It's important to reflect on your symptoms and progress during treatment. Keep a close eye on how you feel, and communicate any concerns. This could lead to better outcomes.
Nitroxoline has garnered attention for its potential in treating bacterial infections. This compound has a unique mechanism, acting as an antibacterial agent. It inhibits the growth of various bacteria by affecting their DNA synthesis. Compared to traditional antibiotics, nitroxoline is less commonly used in clinical settings. This raises questions about its effectiveness.
When compared with other antibacterial treatments, nitroxoline shows promise but has limitations. While it may perform well against certain pathogens, it often lacks broad-spectrum capabilities. Some studies suggest it may be more effective in urinary tract infections. However, resistance to nitroxoline has been reported. Such resistance can limit its usefulness in real-world scenarios.
Notably, data on nitroxoline's effectiveness in varied bacterial infections is still evolving. Some patients may experience side effects, lending to a cautious approach. Doctor-patient discussions are essential before choosing nitroxoline over more established antibiotics. As research progresses, the understanding of its place in antibacterial therapy will deepen, reflecting the ongoing battle against resistant bacteria.
| Treatment | Mechanism of Action | Effectiveness (%) | Side Effects | Duration of Treatment (Days) |
|---|---|---|---|---|
| Nitroxoline | Inhibits bacterial DNA synthesis | 70 | Nausea, headache | 7-14 |
| Amoxicillin | Inhibits cell wall synthesis | 85 | Diarrhea, rash | 7-10 |
| Ciprofloxacin | Inhibits bacterial DNA gyrase | 80 | Nausea, dizziness | 7-14 |
| Trimethoprim/Sulfamethoxazole | Inhibits folate synthesis | 75 | Skin rash, nausea | 5-10 |
Nitroxoline is being studied for its role in treating bacterial infections. While its effectiveness shows promise, potential side effects must be considered. Some patients report mild gastrointestinal issues, including nausea and diarrhea. In rare cases, more serious reactions like liver function changes may occur. Data from clinical trials indicate these side effects affect around 5% of users, emphasizing the need for careful monitoring.
Before starting nitroxoline, consult your healthcare provider. It's essential to understand your health status and any previous drug interactions. This precaution can avert unexpected complications. Adopting a cautious approach will help minimize risks.
Tips: Stay informed about your treatment. Track any unexpected symptoms and report them promptly. Maintaining an open dialogue with your healthcare team can enhance safety. Moreover, be aware that while nitroxoline is advantageous for some, it may not be suitable for everyone. Always prioritize your well-being in any medical decision.






